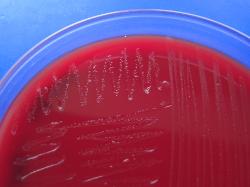

| Lactococcus lactis & Lactococcus cremoris |
| Lactococcus lactis subsp. lactis on Blood Agar |
Taxonomy
Morphology
Cultural characteristics
Biochemical characters
Ecology
Pathogenicity
References
Phylum Bacillota (Firmicutes), Class Bacilli, Order Lactobacillales, Family Streptococcaceae, Genus Lactococcus, Lactococcus lactis
(Lister 1873) Schleifer et al. 1986. Type species of the genus.
Reacts with Lancefield serological group N antiserum.
Lactococcus lactis subspecies:
- Lactococcus lactis subsp. lactis (Lister 1873) Schleifer et al. 1986. Synonyms: Streptococcus lactis (Lister 1873) Lohnis 1909,
Streptococcus lactis subsp. lactis (Lister 1873) Garvie and Farrow 1982, Bacterium lactis Lister 1873;
- Lactococcus lactis subsp. hordniae (ex Latorre-Guzman et al. 1977) Schleifer et al. 1986. Synonym: Lactobacillus hordniae
Latorre-Guzman et al. 1977.
Lactococcus cremoris subspecies:
- Lactococcus cremoris subsp. cremoris (Orla-Jensen 1919) Li et al. 2021. Synonyms: Lactococcus lactis subsp. cremoris (Orla-Jensen
1919) Schleifer et al. 1986. Streptococcus cremoris Orla-Jensen 1919, Streptococcus lactis subsp. cremoris (Orla-Jensen 1919) Garvie
and Farrow 1982, Streptococcus hollandicus Scholl 1891, Streptococcus lactis B Ayers et al. 1924;
- Lactococcus cremoris subsp. tructae (Perez et al. 2011) Li et al. 2021. Synonym: Lactococcus lactis subsp. tructae Perez et al. 2011.
Note: L. lactis subsp. lactis also includes the strains of Streptococcus lactis subsp. diacetilactis (ex Matuszewski et al. 1936) Garvie and
Farrow 1982; and the strains of Lactobacillus xylosus Kitahara 1938.
(Lister 1873) Schleifer et al. 1986. Type species of the genus.
Reacts with Lancefield serological group N antiserum.
Lactococcus lactis subspecies:
- Lactococcus lactis subsp. lactis (Lister 1873) Schleifer et al. 1986. Synonyms: Streptococcus lactis (Lister 1873) Lohnis 1909,
Streptococcus lactis subsp. lactis (Lister 1873) Garvie and Farrow 1982, Bacterium lactis Lister 1873;
- Lactococcus lactis subsp. hordniae (ex Latorre-Guzman et al. 1977) Schleifer et al. 1986. Synonym: Lactobacillus hordniae
Latorre-Guzman et al. 1977.
Lactococcus cremoris subspecies:
- Lactococcus cremoris subsp. cremoris (Orla-Jensen 1919) Li et al. 2021. Synonyms: Lactococcus lactis subsp. cremoris (Orla-Jensen
1919) Schleifer et al. 1986. Streptococcus cremoris Orla-Jensen 1919, Streptococcus lactis subsp. cremoris (Orla-Jensen 1919) Garvie
and Farrow 1982, Streptococcus hollandicus Scholl 1891, Streptococcus lactis B Ayers et al. 1924;
- Lactococcus cremoris subsp. tructae (Perez et al. 2011) Li et al. 2021. Synonym: Lactococcus lactis subsp. tructae Perez et al. 2011.
Note: L. lactis subsp. lactis also includes the strains of Streptococcus lactis subsp. diacetilactis (ex Matuszewski et al. 1936) Garvie and
Farrow 1982; and the strains of Lactobacillus xylosus Kitahara 1938.
Gram-positive ovoid cells elongated in the direction of the chain. Grouped mostly in
pairs or short chains. Nonmotile. Endospores are not formed.
pairs or short chains. Nonmotile. Endospores are not formed.
Colonies on blood agar or nutrient agar are nonpigmented, circular, smooth, and
entire. Nonhemolytic, but some strains may produce a weak alpha-hemolysis. Grow
at 10 ºC but not at 45 ºC. Grow in 0.1% methylene blue milk and 2% NaCl.
Facultatively anaerobic.
entire. Nonhemolytic, but some strains may produce a weak alpha-hemolysis. Grow
at 10 ºC but not at 45 ºC. Grow in 0.1% methylene blue milk and 2% NaCl.
Facultatively anaerobic.
Subspecies "cremoris" and "lactis" have been isolated from raw milk, dairy products,
whey, milking machines, and the udders, the saliva and on the skin of cows and
bulls, grass, soil, silage, plant material, including fresh and frozen corn, corn silks,
navy beans, cabbage, lettuce, peas, wheat middlings, grass, clover, potatoes,
cucumbers, and cantaloupe.
Strains of L. lactis subsp. lactis have been also isolated from the intestinal tracts of
freshwater fish, milk from cows with mastitis, tonsils of cats, dogs and goats.
Subspecies "hordniae" has been isolated from the leafhopper Hordnia circellata.
Subspecies "tructae" has been isolated from the intestinal mucus of brown trout
(Salmo trutta) and rainbow trout (Oncorhynchus mykiss).
Lactococci are usually not found in fecal material or soil. They can survive only hours
in the intestinal tract.
Several L. lactis subsp. lactis strains can produce bacteriocins (nisin A and Z) which
can inhibit the growth of a wide range of Gram-positive bacteria.
whey, milking machines, and the udders, the saliva and on the skin of cows and
bulls, grass, soil, silage, plant material, including fresh and frozen corn, corn silks,
navy beans, cabbage, lettuce, peas, wheat middlings, grass, clover, potatoes,
cucumbers, and cantaloupe.
Strains of L. lactis subsp. lactis have been also isolated from the intestinal tracts of
freshwater fish, milk from cows with mastitis, tonsils of cats, dogs and goats.
Subspecies "hordniae" has been isolated from the leafhopper Hordnia circellata.
Subspecies "tructae" has been isolated from the intestinal mucus of brown trout
(Salmo trutta) and rainbow trout (Oncorhynchus mykiss).
Lactococci are usually not found in fecal material or soil. They can survive only hours
in the intestinal tract.
Several L. lactis subsp. lactis strains can produce bacteriocins (nisin A and Z) which
can inhibit the growth of a wide range of Gram-positive bacteria.
Subspecies "cremoris" and "lactis" are used as starter cultures for the manufacture of fermented dairy products like cheeses, sour
milk, and sour cream. Lactococcus lactis subsp. lactis biovar diacetylactis produce diacetyl, an aromatic compound.
Generally they are not pathogenic, but have been rarely isolated from human cases of urinary tract and wound infections, and from
patients with endocarditis.
milk, and sour cream. Lactococcus lactis subsp. lactis biovar diacetylactis produce diacetyl, an aromatic compound.
Generally they are not pathogenic, but have been rarely isolated from human cases of urinary tract and wound infections, and from
patients with endocarditis.
- Tania Perez, Jose Luis Balcazar, Alvaro Peix, Angel Valverde, Encarna Velazquez, Ignacio de Blas, and Imanol Ruiz-Zarzuela
Lactococcus lactis subsp. tructae subsp. nov. isolated from the intestinal mucus of brown trout (Salmo trutta) and rainbow trout
(Oncorhynchus mykiss). Int J Syst Evol Microbiol August 2011. - Matters Relating to the International Committee on Systematic Bacteriology: Validation of the Publication of New Names and New
Combinations Previously Effectively Published Outside the IJSB:List No. 20. Int J Syst Bacteriol April 1986 36:354-356. - Michael Teuber, 2009. Genus II. Lactococcus Schleifer, Kraus, Dvorak, Kilpper-Balz, Collins and Fischer 1986, 354 VP. In: (Eds.) P.
D. Vos, G. Garrity, D. Jones, N.R. Krieg, W. Ludwig, F.A. Rainey, K.-H. Schleifer, W.B. Whitman. Bergey’s Manual of Systematic
Bacteriology, Volume 3: The Firmicutes, Springer, 711-722. - Ellen I. Garvie and John A. E. Farrow. NOTES: Streptococcus lactis subsp. cremoris (Orla-Jensen) comb. nov. and Streptococcus
lactis subsp. diacetilactis (Matuszewski et al.) nom. rev., comb. nov. Int J Syst Bacteriol October 1982 32:453-455. - M. D. Collins, J. A. E. Farrow, B. A. Phillips, and O. Kandler. Streptococcus garvieae sp. nov. and Streptococcus plantarum sp. nov.
J Gen Microbiol November 1983 129:3427-3431. - Li TT, Tian WL, Gu CT. Elevation of Lactococcus lactis subsp. cremoris to the species level as Lactococcus cremoris sp. nov. and
transfer of Lactococcus lactis subsp. tructae to Lactococcus cremoris as Lactococcus cremoris subsp. tructae comb. nov. Int J Syst
Evol Microbiol 2019; 71:0. - Heo J, Cho H, Tamura T, Saitou S, Park K, Kim JS, Hong SB, Kwon SW, Kim SJ. Lactococcus allomyrinae sp. nov., isolated from
gut of larvae of Allomyrina dichotoma. Int J Syst Evol Microbiol 2019; 69:3682-3688. - Pheng S, Han HL, Park DS, Chung CH, Kim SG. Lactococcus kimchii sp. nov., a new lactic acid bacterium isolated from kimchi. Int
J Syst Evol Microbiol 2020; 70:505-510.
Positive results for esculin hydrolysis, leucine arylamidase, acid production from:
glucose, fructose, mannose, N-acetylglucosamine, and trehalose. Most strains
produce acid from arbutin, cellobiose, beta-gentiobiose, and salicin. A few strains are
pyrrolidonylarylamidase positive. Some strains (L. lactis subsp. lactis biotype
diacetilactis) can utilize citrate.
Negative results for alkaline phosphatase, alpha-galactosidase, beta-galactosidase,
beta-glucuronidase, catalase, acid production from: D- or L-arabinose, D- or
L-arabitol, adonitol, 2-ketogluconate, 5-ketogluconate, dulcitol, erythritol, D-fucose,
L-fucose, gluconate, glycerol, glycogen, inositol, inulin, melezitose, alpha-methyl-
D-glucoside, alpha-methyl-D-mannoside, D-lyxose, rhamnose, L-sorbose, sorbitol,
D-tagatose, D-turanose, xylitol, and L-xylose. Most strains of L. lactis subsp. cremoris
do not produce acid from beta-gentiobiose, salicin, and trehalose.
Variable results for acid production from arbutin and starch.
glucose, fructose, mannose, N-acetylglucosamine, and trehalose. Most strains
produce acid from arbutin, cellobiose, beta-gentiobiose, and salicin. A few strains are
pyrrolidonylarylamidase positive. Some strains (L. lactis subsp. lactis biotype
diacetilactis) can utilize citrate.
Negative results for alkaline phosphatase, alpha-galactosidase, beta-galactosidase,
beta-glucuronidase, catalase, acid production from: D- or L-arabinose, D- or
L-arabitol, adonitol, 2-ketogluconate, 5-ketogluconate, dulcitol, erythritol, D-fucose,
L-fucose, gluconate, glycerol, glycogen, inositol, inulin, melezitose, alpha-methyl-
D-glucoside, alpha-methyl-D-mannoside, D-lyxose, rhamnose, L-sorbose, sorbitol,
D-tagatose, D-turanose, xylitol, and L-xylose. Most strains of L. lactis subsp. cremoris
do not produce acid from beta-gentiobiose, salicin, and trehalose.
Variable results for acid production from arbutin and starch.
(c) Costin Stoica

| Antibiogram |
| Encyclopedia |
| Culture media |
| Biochemical tests |
| Stainings |
| Images |
| Movies |
| Articles |
| Identification |
| Software |
| R E G N U M PROKARYOTAE |
Legend: + positive 90-100%, - negative 90-100%, [+] positive 75-89%, [-] negative 75-89%, d positive 25-74% of strains
|
Differential characters of Lactococcus lactis subspecies:
|



| Back |